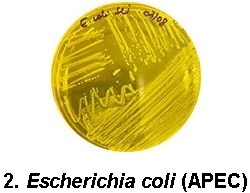

Contenido patrocinado por:
BioCamp Laboratórios
Pos-eclosión: puntos críticos que afectan el desarrollo inicial de las aves
Publicado: 6 de octubre de 2021
Por: Bauer Alvarenga, Gerente de Negocios en Biocamp
La calidad de los pollitos de un día debe tenerse en cuenta incluso antes de la eclosión. Eso es lo que el Director Técnico y Comercial de Biocamp, Paulo Martins, abordó en un artículo recientemente publicado aquí en el blog de Biocamp. El tema es bastante pertinente en un momento en el que vemos empresas enfrentando problemas de onfalitis en sus lotes – y también cuando hay constantes alertas de organismos como la Organización Mundial de la Salud (OMS) para controlar el uso de antimicrobianos y la aparición de bacterias multirresistentes.

El contenido presentado preparó el terreno para lo que hablo en este artículo: si el cuidado con la calidad de los lotes comienza antes de que nazcan los pollitos, ciertamente continúa en el momento pos-eclosión, siendo fundamental para el desarrollo inicial – y futuro – de las aves. Pero, ¿cuáles son los puntos críticos que deben monitorearse en este período? De eso hablaremos a continuación.
Los riesgos biológicos y físicos
Cuando se habla de puntos críticos que afectan el desarrollo inicial de las aves, es necesario pensar en toda la cadena involucrada: el sistema de producción de las reproductoras, el proceso de incubación, el transporte a las granjas y el manejo inicial. Y, yendo más allá, es necesario pensar todo esto de manera integrada, ya que todos traen impactos significativos en este inicio de la vida del ave.
¿Qué caracteriza la calidad de los pollitos de un día?
Empecemos por el principio: ¿qué significa tener calidad? Se deben cumplir algunos criterios, tanto al pensar en pollos de engorde como en gallinas ponedoras. A continuación he enumerado los principales:


Tener esto en cuenta es fundamental para comprender qué afecta la calidad de estos pollitos, especialmente considerando los riesgos biológicos y físicos a los que están expuestos.
Por mucho que el foco de los productores esté en pollitos de calidad y libres de contaminación (concepto FREE) y los profesionales del sector avícola se esfuercen por mantener los riesgos al mínimo, no siempre es así, ya que la ausencia total de estos factores biológicos y los físicos prácticamente no forman parte de la producción agroindustrial.
Por lo tanto, es posible que se pregunte: ¿cuáles son estos riesgos y qué puede hacer para minimizarlos? Esto es lo que les presento a continuación.
Comprensión de los riesgos biológicos
Las contaminaciones más frecuentes – y presentes en nuestra vida diaria – son las provocadas por Enterobacterias, como Salmonella spp., Escherichia coli (APEC) y Pseudomonas aeruginosa, y por el hongo Aspergillus niger.
Los 4 tipos de contaminación son diversos y pueden originarse en las reproductoras, la planta de incubación o incluso el galpón donde se alojarán los pollitos.

Provocan dos problemas principales que, a pesar de tener el mismo patógeno, provocan enfermedades con diferentes impactos:
1.1 Paratifoidea: esto genera principalmente problemas de salud pública y no necesariamente una enfermedad para las aves; por lo tanto, un pollito positivo con salmonela paratífica es capaz de transformarse en pollos de engorde;
1.2 Tifoidea aviar y Pullorosis: presentan mayor letalidad, impactando el resultado zootécnico.

La mayoría de las empresas hoy en día han informado de algún tipo de problema con esta bacteria, que tiene un papel directo en la onfalitis – a pesar de su influencia directa, la mayoría de las veces, no es la única bacteria que causa la enfermedad.

Como guardan silencio, las empresas generalmente solo notan la presencia de la bacteria cuando el problema ya ha aparecido, lo que puede resultar en la mortalidad o el rechazo de los pollitos recién nacidos, lo que puede comprometer el resultado en su conjunto.

El hongo puede ser tanto un problema de la planta de incubación como de granja.
Riesgos físicos
En cuanto a los riesgos físicos, los 6 principales son:
1. Deshidratación: puede ocurrir tanto en el manejo de la incubación como en el manejo inicial de la granja. Se puede detectar mirando la pierna del pollito, que muestra fácilmente el grado de hidratación — cuanto más expuesta está la vascularización, mayor es el grado de deshidratación.
2. Ombligo abierto: problema generalmente relacionado con la temperatura de incubación alta, pero también puede ser de origen bacteriano.
3. Locomotoras: este tipo de problemas pueden originarse en la planta de incubación o en el transporte de pollitos que tienen su desarrollo afectado y, automáticamente, no podrán traer los resultados esperados.
4. Plumón: puede ocurrir ausencia de plumón, plumón quemado o melaza. Estos no son necesariamente problemas que comprometan el desarrollo del ave, por lo que es importante tener sentido común y hacer una valoración que pueda escalar las fallas para entender si realmente es un punto crítico.
5. Malformaciones: los pollitos que presenten este tipo de problema deben ser retirados completamente en la planta de incubación. Estos pollitos no deben salir al campo bajo ninguna circunstancia.
6. No uniformidad: en este ítem, una vez más, debe prevalecer el sentido común y son aceptables pequeñas variaciones de peso. Siempre tenemos que pensar en cuánto afectará esto realmente al desarrollo inicial del lote.
Sin duda, estos son los principales riesgos biológicos y físicos que pueden afectar el desarrollo temprano de las aves. Aún así, debemos tener en cuenta que rara vez alojaremos lotes que sean completamente libres de problemas. Depende de nosotros los técnicos no solo evaluar y cuantificar su presencia, sino principalmente identificar su origen y visualizar en qué medida cada problema puede comprometer la productividad de los lotes.
La microbiota intestinal y su relación con la calidad del pollito
La microbiota de las aves no es estática. Y existen varios factores ambientales que pueden interferir en su composición y equilibrio: edad, genética, segmento intestinal, sexo, alimentación, ambiente, higiene, medicamentos, temperatura, cama, entre otros.
Está compuesto por microorganismos, especialmente bacterias, que habitan en los intestinos de las aves y son responsables de la producción de energía, vitaminas, enzimas y desempeñan funciones esenciales para su salud y rendimiento.
La formación y el equilibrio de la microbiota intestinal se puede dividir en tres fases distintas:
1. Colonización: desde el final del período de incubación hasta el 3er día de vida. Antes del nacimiento, la microbiota es rudimentaria y aumentará significativamente en cantidad y diversidad en los primeros tres días de vida;
2. Maduración de la colonización: del 4o al 14o día, el sistema digestivo y la microbiota intestinal pasarán juntos por un proceso de maduración. Es en este punto que el sistema digestivo ajusta la producción de HCl, bilis, enzimas y establece diferentes niveles de pH en todo el intestino. Como resultado, la microbiota se modulará a medida que avanza el proceso de maduración.
3. Mantenimiento del equilibrio (eubiosis): después del 15o día, se establece la microbiota. Habrá una competencia más intensa entre bacterias comensales y patógenas, lo que puede comprometer su equilibrio y, en consecuencia, la salud de las aves. Cuando está en equilibrio, la microbiota es responsable de la producción de enzimas, bacteriocinas, energía y vitaminas que contribuirán a la integridad intestinal y la respectiva ganancia zootécnica.
Conceptos integrados
Son varios los factores que inciden en la calidad de los pollitos de un día y es IMPRESCINDIBLE pensar en ellos de forma integrada. Si la microbiota no es estática, es decir, está en constante competencia, los profesionales avícolas deben prestar atención a las tres fases mencionadas anteriormente y, por tanto, mantener la eubiosis a lo largo de toda la cadena productiva. El cuidado comienza el primer día de vida de las reproductoras (influencia vertical) y el control de la microbiota ya debería ser una prioridad allí. Los riesgos de contaminación horizontal, que pueden estar presentes en la cama, por ejemplo, deben ser considerados y monitoreados antes del alojamiento.
Entonces, ¿cómo trabajar para promover este equilibrio? Hoy en día, los prebióticos, fitoterápicos, ácidos orgánicos y probióticos ofrecen una acción directa en el control de la eubiosis y están indicados para ello. Además, otros factores como la nutrición, el ambiente y los diferentes manejos también pueden favorecer o no la eubiosis. No podemos olvidarnos de los propios antibióticos, que afectan a la microbiota cuando hay necesidad de tratamiento.
Por lo tanto, al diseñar un programa de salud, estos factores deben considerarse de manera única. Independientemente del contexto en el que se desarrolle esta producción.
Colonización temprana: beneficios
La modulación de la microbiota es la mejor forma de lograr la eubiosis. Y cuanto antes suceda, mejor. Esto significa que debe comenzar todavía en el la planta de incubación, con probióticos de múltiples cepas o de exclusión competitiva que conformarán la microbiota pionera, favoreciendo las ganancias zootécnicas, estimulando el sistema inmunológico y dificultando la colonización de bacterias patógenas que pueden estar presentes en el alimento, el agua y el ambiente de producción de las aves.
Por lo tanto, la colonización temprana, que puede ocurrir “in ovo” o poco después del nacimiento, a través del aerosol, es esencial para el comienzo de la vida del ave, para la formación de la microbiota pionera y, automáticamente, para que esta ave supere los desafíos. todavía dentro de la planta de incubación.
Probióticos
Si los probióticos se alían para promover este equilibrio de la microbiota intestinal, es posible que se pregunte cuál es el mejor para su negocio. La línea Colostrum® de Biocamp es amplia y eficaz para controlar los diversos desafíos de la producción avícola.
Temas relacionados:
Recomendar
Comentar
Compartir

¿Quieres comentar sobre otro tema? Crea una nueva publicación para dialogar con expertos de la comunidad.